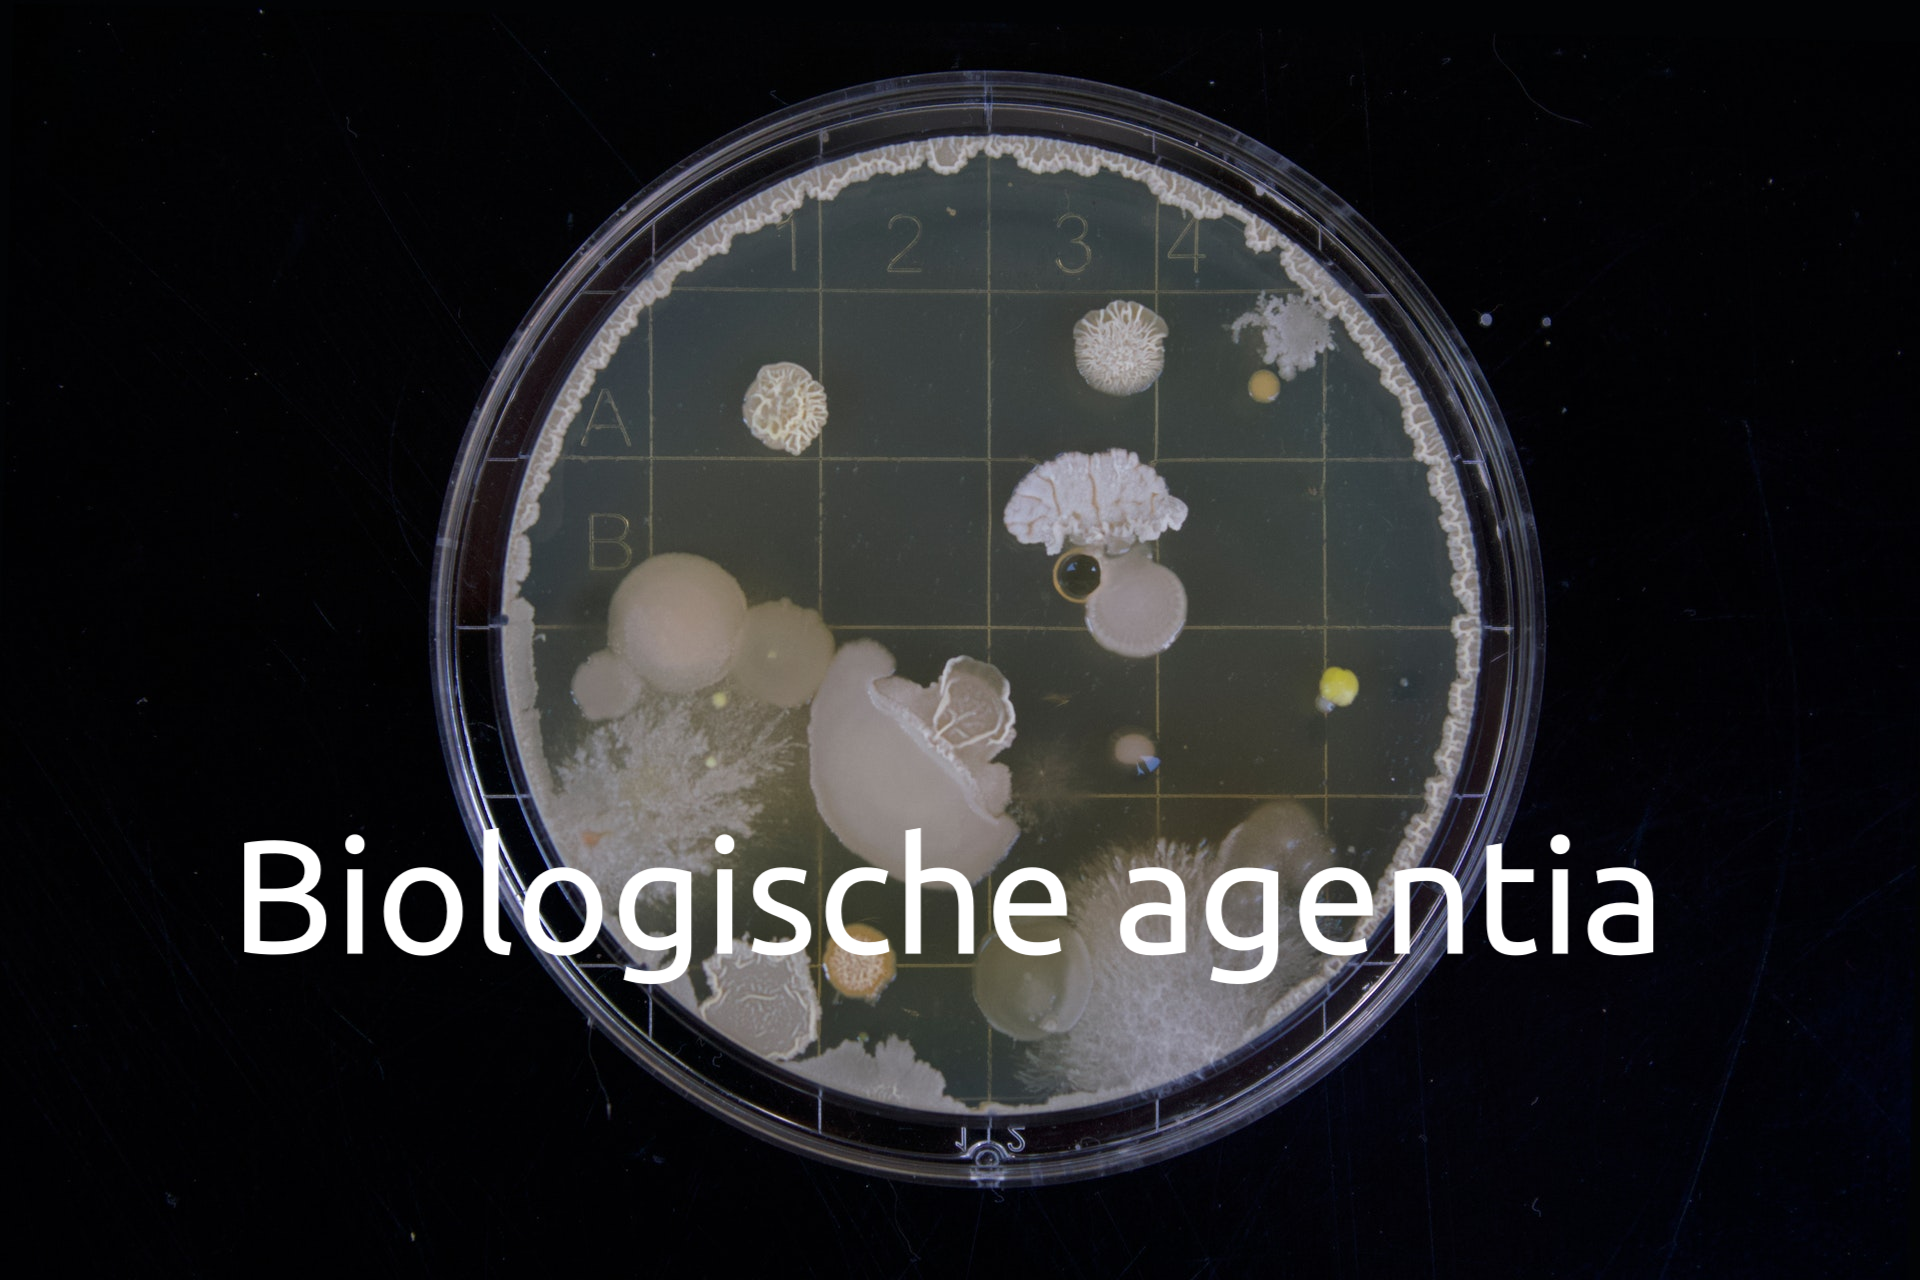

RISICOMANAGEMENT
Risicomanagement is bedoeld om risico's in beeld te krijgen en daarop maatregelen te treffen om deze risico's te elimineren zodat een beheersbare werksituatie kan voort blijven bestaan. Ik kan uw organisatie adviseren en ondersteunen bij het opstellen, uitvoeren en ontwikkelen van diverse instrumenten op gebied van risicomanagement. Heeft u vragen of wilt u meer weten hierover?
ONDERZOEKEN & ADVIES
Op gebied van onderzoek en advies ben ik breed inzetbaar om uw organisatie daarin te ondersteunen. Op diverse onderwerpen kan advies en ondersteuning geboden worden bij de inrichting van het proces, de beschrijving van de werkwijze in een werkprocedure, het geven van voorlichting/workshop, de toetsing van de huidige situatie door werkplekinspecties. Daarnaast kan ik onderzoek verrichten door metingen te verrichten op klimaat, micro-organismen, (kwarts)stof en geluid. Ligt uw organisatiebehoefte op een ander vlak dan kunt u geheel vrijblijvend een afspraak met mij maken om de mogelijkheden te bespreken.